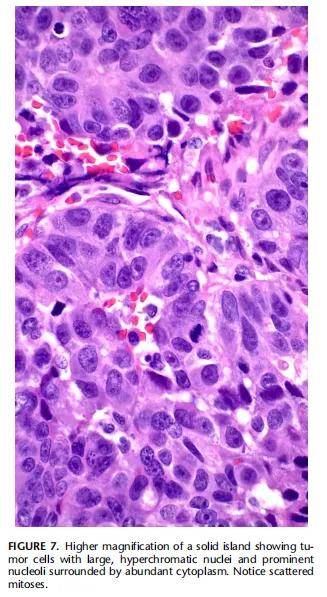

本文描述了一种与大细胞神经内分泌癌高度相似的独特肺腺癌形态。肿瘤发生于 6 名女性和 6 名男性,年龄 46-86 岁(平均 58.4 岁)。患者表现为周围性胸膜下肿块,大小 2-12 cm(平均 6.5 cm)。组织学特征为大的非典型细胞呈巢状或吻合性蛇形条索排列,可见显著的核周围栅栏状排列、高有丝分裂活性及明显的粉刺样坏死区。由于与神经内分泌肿瘤的显著相似性,尽管缺乏神经内分泌标记物,部分病例最初被诊断为大细胞神经内分泌癌。免疫组织化学显示肿瘤细胞甲状腺转录因子1(TTF1)和 napsin-A 阳性,p40 阴性。肿瘤对多种神经内分泌标记物(包括嗜铬粒蛋白、突触素、CD56和INSM1)均呈阴性。2 例患者的电子显微镜检查未发现膜结合的致密核心神经分泌颗粒。8 例肿瘤通过二代测序检测,其中5例检测到致病性改变。5 例患者检测到KRAS和TP53点突变。2 例患者存在GNAS、KIT和FGFR1低水平扩增。未发现RB1突变。10 例患者的临床随访显示,2 例患者因肿瘤死亡,2 例发生远处转移,6 例在诊断后 1-13 年(中位 7.1 年)存活良好。肺大细胞基底样腺癌(large-cell basaloid adenocarcinoma of the lung)是一种罕见的肺癌亚型,易与大细胞神经内分泌癌混淆。认识这种罕见的肺腺癌亚型对治疗、预后评估及避免误诊具有重要意义。
背 景
在过去 20 年中,随着新工具的出现助力这些肿瘤的诊断,肺癌的分类取得了显著进展。免疫组织化学和分子病理学对我们理解和定义这些肿瘤做出了重大贡献。世界卫生组织(WHO)目前将肺癌分为 4 大类:腺癌、鳞状细胞癌、大细胞癌和肉瘤样癌。此外,还确认了第五组上皮源性肿瘤,属于广义的神经内分泌肿瘤范畴。大细胞神经内分泌癌(LCNEC)是一种神经内分泌肿瘤,WHO将其定义为具有神经内分泌形态且每 2 mm²有丝分裂计数超过 10 个的高级别非小细胞癌,其表达 1 种或多种神经内分泌免疫组织化学标记物。诊断LCNEC通常需要至少 1 种神经内分泌标记物的强表达。WHO指出,大多数肿瘤会表达 2 或 3 种标准神经内分泌标记物(嗜铬粒蛋白、突触素和CD56),且其中至少 1 种标记物的表达通常呈弥漫性。关于量化这些标记物表达程度的更严格标准,或关于哪些标记物可作为神经内分泌分化明确证据的更详细定义,目前尚未达成共识,但普遍认为神经内分泌标记物的表达是诊断的基本要求。本文研究了 12 例肺肿瘤,其形态学与LCNEC高度相似,但神经内分泌相关标记物阴性;相反,这些肿瘤通过免疫组织化学标记为腺癌(TTF1+/Napsin+)。研究人员认为这些肿瘤代表了一个与LCNEC不同且独立的实体。本文将呈现并讨论这些肿瘤的临床病理、免疫组织化学、超微结构及分子遗传学特征。
研究方法
本文所述特征的 12 例病例,源自作者所属机构的手术病理档案,以及其中一位作者 1990 年至 2020 年间的个人会诊档案。每例病例均提供了代表性苏木精-伊红(H&E)染色玻片用于复核;所有病例均提供了石蜡块或未染色玻片用于免疫组织化学检测,其中 8 例提供了相关材料用于分子病理学研究。2 例病例通过湿福尔马林固定材料重新处理后进行了电子显微镜检查。患者的临床特征通过其病历记录或转诊医生获取。提取的临床信息包括:年龄、性别、临床表现、病变大小及位置、病理分期、治疗方式及临床随访情况。本研究经机构审查委员会批准开展。
免疫组化
所有病例的代表性组织切片均切成 4 μm厚,免疫组织化学染色使用试剂盒及染色机完成,方法如前所述。免疫组织化学反应根据不同抗体的核、胞质或膜反应性判定为阳性。当阳性反应涉及肿瘤细胞且至少影响 50% 的肿瘤细胞群体时,视为有意义阳性。对于神经内分泌标记物,任何程度的阳性反应均视为“阳性”,仅当切片完全阴性时方视为“阴性”。检测的抗体包括:细胞角蛋白AE1/AE3;CK7;TTF1;p40;napsin-A;Ki-67;CD56;p16;嗜铬粒蛋白;突触素;PD-L1(Dako,抗体克隆号22C3)及INSM-1。染色程度记录为阴性(0%)、轻度(1%-25%)、中度(25%-50%)及强弥漫性(>50%)。Ki-67表达通过手动计数 100 个连续细胞中的阳性核进行半定量分析。
电子显微镜
对于电子显微镜检查,病例6和病例8的湿组织从福尔马林缓冲液中取出,切成 1 mm³立方块,经戊二醛后固定,包埋于环氧树脂,按常规流程进行电子显微镜处理。通过半薄切片复核肿瘤细胞定位,超薄切片经醋酸铀和柠檬酸铅染色后,在电子显微镜下观察。每例至少观察 5 个载网。
下一代测序(NGS)
使用DNA/RNA纯化试剂盒,从福尔马林固定石蜡包埋(FFPE)的肿瘤组织样本中提取高质量DNA和RNA。随后进行文库制备、模板制备、测序及比对。该检测设计用于分析 50 个癌症相关基因的突变(包括DNA热点区域:AKT1、CHEK2、FGFR3、KIT、NTRK3、AKT2、CTNNB1、FGFR4、KRAS、PDGFRA、AKT3、EGFR、FLT3、MAP2K1、PIK3CA、ALK、ERBB2、GNA11、MAP2K2、PTEN、AR、ERBB3、GNAQ、MET、RAF1、ARAF、ERBB4、GNAS、MTOR、RET、BRAF、ESR1、HRAS、NRAS、ROS1、CDK4、FGFR1、IDH1、NTRK1、SMO、CDKN2A、FGFR2、IDH2、NTRK2、TP53);拷贝数变异(CNV,涉及基因:ALK、FGFR1、AR、FGFR2、CD274、FGFR3、CDKN2A、KRAS、EGFR、MET、ERBB2、PIK3CA、ERBB3、PTEN);以及多个基因的融合(ALK、NTRK1、BRAF、NTRK2、ESR1、NTRK3、FGFR1、NUTM1、FGFR2、RET、FGFR3、ROS1、MET、RSPO2、NRG1、RSPO3、AR、EGFR、MET)。测序仪生成的DNA FASTQ reads通过Genexus流程处理:经Torrent比对程序(TMAP)比对后,使用Ion Torrent变异检测软件(TVC)识别单核苷酸变异(SNVs)和插入缺失变异(INDELs)。拷贝数变异(CNV)通过Genexus流程处理后的去重BAM文件,利用CNVkit变异检测软件判定。CNV阈值分别为 0 个拷贝和 ≥6 个拷贝(分别表示基因拷贝数的缺失和扩增)。
研究结果
临床结果
患者的临床特征详见表1。患者包括 6 名女性和 6 名男性,年龄 46-86 岁(平均 58.4 岁)。半数患者有吸烟史,多数临床表现为咳嗽、胸痛、气短及咯血。2 例患者因其他原因行胸部X线或CT扫描时偶然发现病变。所有患者均接受肿瘤完全手术切除(3 例经楔形切除术,9 例经肺叶切除术)。肿瘤均位于胸膜下,最大直径 2-12 cm(平均 6.5 cm);大体观察呈无包膜浸润性生长,切面灰白,可见坏死区域;6 例位于右下叶,4 例位于右上叶,1 例位于左上叶,1 例位于左下叶。1 例患者为pT1b期,4 例为pT2期,1 例为pT3期,6 例为pT4期。6 例患者手术时存在区域淋巴结转移。2 例患者术后接受胸壁或纵隔放疗,4 例接受全身化疗。10 例患者有临床随访资料:2 例分别于术后 2 年和 4 年因肿瘤死亡;6 例确诊后 1-13 年(中位 7.1 年)生存良好;2 例分别发生骨和脑远处转移;2 例失访。

▲表1 12例患者的临床病理表现
组织病理学结果
所有肿瘤均表现出相似的组织学特征。低倍镜下观察,肿瘤表现为浸润性细胞岛和细胞索,核周栅栏状排列显著,其间为胶原性(常呈促纤维增生性)间质分隔(图1)。肿瘤边界不清、呈浸润性生长,且常见周边沿肺泡腔扩散。所有肿瘤均可见广泛坏死区域;显著特征为肿瘤细胞岛内出现粉刺样中央坏死区(部分融合形成更大的地图状坏死区)(图2)。匐行性小梁状或条索状生长模式区域也是突出特征(图3)。肿瘤细胞岛呈现两种细胞群体:外层由大的圆形至多边形细胞组成,胞质丰富,核位于基底部;内层核心细胞则以大的中央位核为特征,周围环绕嗜酸性胞质环(图4)。3 例病例中,细胞岛中央区域可见显著胞质透亮(细胞边界清晰)(图5)。所有病例均可见规则的小“穿凿样”管腔结构——低倍镜下类似菊形团,但高倍镜下显示为单层细胞衬覆的腺管结构,管腔内有时含嗜酸性分泌物或坏死碎屑(图6A、B)。部分区域因腺管密集,使细胞岛呈现筛状外观。高倍镜下,肿瘤细胞显示显著细胞非典型性,核质比相对较高,染色质密度增加,核仁明显(图7)。许多细胞可见丰富的嗜酸性胞质环。核分裂象(包括异常核分裂)常见(每2 mm² >10个)。肿瘤组织学较单一,未显示与经典腺泡型腺癌或其他类型肺癌的移行或相关证据。

▲图1 病例1的镜下结果

▲图2(左)病例1镜下结果;和图3(右)病例2的镜下结果

▲图4(左)病例5的镜下结果;和图5(右)病例6的镜下结果

▲图6 外周栅栏状排列及可能的筛状结构
▲图7 高倍镜下可见实体岛状结构,肿瘤细胞核大而深染,核仁明显,胞质丰富,可见散在的核分裂象
免疫组化结果
免疫组织化学染色结果详见表2。所有肿瘤对甲状腺转录因子1(TTF1)、天冬氨酸蛋白酶A(napsin-A)、细胞角蛋白AE1/AE3(cytokeratin AE1/AE3)、细胞角蛋白7(CK7)及p16呈强阳性(图8A、B)。嗜铬粒蛋白(chromogranin)、突触素(synaptophysin)、CD56及INSM1染色在所有检测病例中均为阴性(病例8因材料不足未行INSM1检测)(图8C、D)。所有肿瘤均检测PD-L1,结果均为阴性(TPS < 1%)。MIB1染色显示增殖活性显著升高(核阳性率 20%-60%,均值 44.5%)。

▲表2 12例患者的免疫组化和分子特征

▲图8 肺大细胞基底样腺癌的免疫组化结果
超微结构结果
2 例病例的电子显微镜检查显示,可见紧密聚集的大细胞群,细胞染色质致密,核仁明显。胞质内可见丰富的粗面内质网、高尔基体、线粒体及散在的溶酶体。细胞膜紧密相邻,可见桥粒样细胞连接;部分区域可见早期管腔形成(伴微绒毛)(图9A、B)。经广泛观察,未发现张力丝、糖原颗粒或致密核心神经分泌颗粒。

▲图9 病例8肿瘤的超微结构
NGS结果
在检测的 8 例肿瘤中,5 例(63%)检测到致病性分子变异(表2)。仅在 2 个基因中发现点突变:KRAS和TP53,其中 2 例(25%)肿瘤存在KRAS突变,3 例(38%)存在TP53突变。3 个基因检测到低水平拷贝数增加:2 例(25%)显示KIT拷贝数增加,1 例(13%)显示GNAS拷贝数增加,1 例(13%)显示FGFR1拷贝数增加。2 例患者表现为携带多个同时性变异,3 例患者仅携带单个变异。3 例未检测到致病性改变或意义未明的变异。
讨 论
本文报道了 12 例易被混淆为大细胞神经内分泌癌(LCNEC)的原发性肺肿瘤病例。尽管部分病例缺乏令人信服的神经内分泌分化证据,仍被最初诊断为LCNEC。尽管这些病例与LCNEC存在某些形态学相似性,但在免疫组织化学或超微结构水平上均未显示任何神经内分泌分化的证据。
“大细胞神经内分泌癌(LCNEC)”这一术语最早由Barbareschi等人于 1989 年在文献中提出。后续针对此类肿瘤诊断难点的研究识别出三种存在显著重叠、从而导致其定义困难的肺癌类型,即:①具有神经内分泌样生长模式但缺乏神经内分泌标记物表达的大细胞癌;②缺乏神经内分泌组织学表现但表达神经内分泌标记物的大细胞癌;③同时具有神经内分泌生长模式和神经内分泌相关标记物表达的“真正”LCNEC。关于LCNEC定义标准的首个提案由Travis等人于 1991 年提出,其建议的标准包括:①光镜下呈现神经内分泌形态;②细胞体积大、呈多边形、核质比低、核染色质粗、常见核仁;③高有丝分裂率(>10/10高倍视野)且常见坏死;④通过免疫组化或电镜显示神经内分泌特征。这些标准基本沿用至今,并被世界卫生组织(WHO)采纳。目前,WHO将LCNEC定义为具有神经内分泌形态、有丝分裂计数 >10 个/2 mm²的高级别非小细胞癌,且需表达 1 种或多种神经内分泌免疫组化标记物。WHO进一步指出,大多数此类肿瘤会表达 2-3 种标准神经内分泌标记物(突触素、嗜铬粒蛋白-A和CD56),且至少 1 种标记物的表达通常为弥漫性;与之不同的是,缺乏神经内分泌形态的非小细胞肺癌可能异常表达神经内分泌标记物,但此类表达通常为局灶性且仅限于单一标记物。尽管WHO对LCNEC的定义已被广泛接受,但该肿瘤仍存在争议且诊断困难,主要原因在于其与其他神经内分泌肿瘤的重叠性,以及缺乏更严格的免疫组化或分子标准来定义神经内分泌分化,甚至在专家之间也难以实现诊断的观察者间高重复性。
如何界定肿瘤属于神经内分泌谱系的问题仍是争议焦点。众所周知,在缺乏神经内分泌分化形态学特征的各类癌症(尤其是肺腺癌)中,局灶性或异常神经内分泌分化是相对常见的现象。此外,当前通过免疫组化定义神经内分泌分化的依据是检测标记物,而这些标记物大多表现出良好的敏感性但特异性较差。因此,当被认为更具特异性的标记物未表达时,支持神经内分泌分化的证据便显得薄弱。例如,最常用的两种标记物——突触素和CD56(神经细胞黏附分子)——具有非常广泛的反应模式,可见于多种非上皮性肿瘤,包括血管肉瘤、横纹肌样肿瘤、神经鞘瘤、透明细胞肉瘤、原始神经外胚层肿瘤、性索-间质肿瘤、树突状神经纤维瘤、致磷酸盐尿性间叶肿瘤、胰腺实性假乳头状肿瘤;此外,也可见于多种上皮性非神经内分泌恶性肿瘤,如甲状腺良恶性肿瘤、乳腺癌、结直肠腺癌、SMARCA4缺陷型鼻窦癌、胰腺浆液性囊腺瘤、肾上腺皮质癌、肺硬化性血管瘤(肺细胞瘤)、胰腺腺泡细胞癌,以及非典型胸腺瘤和胸腺癌。因此,突触素和CD56属于非特异性标记物,无法完全依赖其确定神经内分泌分化谱系。在WHO推荐的 3 种标记物中,嗜铬粒蛋白-A是唯一具有足够特异性的标记物,因其定位于肿瘤细胞的致密核心神经分泌颗粒内。近年来,已开发出更具特异性的神经内分泌分化标记物,为这类肿瘤的识别带来了新希望。其中研究最广泛的标记物是胰岛素瘤相关蛋白-1(INSM-1),多数研究发现其是肺肿瘤神经内分泌分化的可靠且敏感的标记物。采用该标记物可能有助于提高LCNEC诊断的特异性。
本研究中的病例在光镜下表现与大细胞神经内分泌癌(LCNEC)极为相似。肿瘤由大多边形细胞构成的条索和岛状结构组成,细胞具有致密染色质模式、高核质比、显著核仁和丰富的有丝分裂象(>10 个/2 mm²);所有肿瘤均显示显著的核周围栅栏状排列,赋予其“基底细胞样”外观。肿瘤细胞岛伴随坏死区域,主要为粉刺型坏死,也可见更广泛的地图状坏死。在许多肿瘤中,细胞岛内存在管腔间隙,表面类似菊形团,但实为腺腔。上述所有特征与文献中对LCNEC的描述及图示高度吻合。然而,尽管与LCNEC形态高度相似,本研究中所有肿瘤的神经内分泌标记物(包括嗜铬粒蛋白和INSM1)检测均为阴性。2例病例进行了电子显微镜检查,广泛搜索后均未发现膜结合的致密核心神经分泌颗粒。本文肿瘤在形态学上也与“具有神经内分泌生长模式但神经内分泌标记物阴性的大细胞癌”组存在重叠。但值得注意的是,除蛋白水平和超微结构水平均缺乏神经内分泌分化外,所有病例的napsin-A和TTF1均呈明确阳性,从而确认其属于肺肿瘤中的腺癌家族。
研究人员对 8 例病例进行了下一代测序分析。仅 5 例检测到分子变异,主要为KRAS和TP53的点突变。3 个基因(KIT、GNAS和FGFR1)检测到低水平拷贝数获得。值得注意的是,所有病例均未出现高级别神经内分泌肿瘤中典型的RB1基因改变。文献中已有多项研究探讨了LCNEC的基因组改变。在Rekhtman等人和George等人的研究中,作者识别出这类肿瘤的两种主要基因组谱亚型:小细胞癌样亚型(“SCLC型”或“II型LCNEC”),以TP53和RB1双等位基因失活为特征(类似于小细胞肺癌中的表现);非小细胞癌样亚型(“NSCLC型”或“I型LCNEC”),以TP53和RB1未同时改变为特征,并常伴随与非小细胞肺癌更相关的突变(如STK11、KRAS和KEAP1)。这种分子异质性可能提示,当前定义下的LCNEC本身是一个异质性实体,这或许可以解释其在免疫组化水平上神经内分泌相关标记物表达的变异性,以及与非神经内分泌性质相似肿瘤的形态学重叠现象。
这些肿瘤的发病机制仍不明确。肺神经内分泌肿瘤谱系十分广泛,涵盖了具有不同生物学特性、临床特征和形态学表现的肿瘤。因此,它们代表了一个异质性类别,与其他明确定义的非神经内分泌肿瘤存在大量重叠案例。这一点在大细胞神经内分泌癌(LCNEC)类别中尤为突出——其神经内分泌标记物的表达存在广泛梯度:从具有典型形态且明确表达多数传统神经内分泌相关标记物的肿瘤,到根据WHO标准可能仅表达 1 种标记物(即使该标记物为非特异性且仅局灶性表达)的肿瘤,均被纳入此范畴。事实上,WHO对大细胞神经内分泌癌(LCNEC)的这一宽泛定义引发了对该实体完整性的质疑——鉴于其推荐并认可为神经内分泌分化确凿阳性证据的标记物中,至少有两种是非特异性的,至多只能作为替代标记物,而非仅限于神经内分泌肿瘤的特异性标记物。此外,Rekhtman等人的研究进一步扩展了LCNEC的范畴。他们报道了 17 例表达napsin-A的LCNEC病例(其中 12 例为局灶性表达,5 例为弥漫性表达,染色强度为弱至中度,无强阳性病例)。该研究中检测的 14 例肿瘤中,11 例还携带肺腺癌典型突变。这些肿瘤的LCNEC诊断基于神经内分泌相关标记物的局灶性表达。研究人员推测,这些发现支持部分LCNEC与肺腺癌存在密切的生物学关联,且可能共享起源细胞。鉴于napsin-A是外分泌分化标记物,且与腺癌存在基因组相似性,作者进一步提出疑问:此类肿瘤是否应被视为“具有神经内分泌分化的腺癌”?本文研究中的病例与Rekhtman描述的肿瘤存在许多相似点,包括神经内分泌样组织学特征、napsin-A的免疫组化表达及部分基因组特征(如RB1缺失);但不同之处在于,本文病例完全缺乏神经内分泌标记物染色,且无神经内分泌分化的超微结构证据。这些肿瘤是否代表LCNEC谱系中神经内分泌标记物完全缺失的极端情况仍存在争议,但在缺乏任何神经内分泌分化证据、且有免疫组化和分子证据支持腺癌表型的情况下,研究人员认为这些肿瘤最适合归类为“具有显著神经内分泌样形态的肺腺癌变异型”。值得强调的是,所有病例中TTF1/napsin-A的强阳性表达,依据WHO现行定义,排除了将其归类为肺大细胞癌变异型的可能。
在长期随访的患者中,4 例在初诊后 6-16 年(平均 9.7 年)仍存活且无疾病证据;而LCNEC和基底样鳞状细胞癌病例已知具有更强的侵袭性。尽管我们研究中的肿瘤与LCNEC和基底样鳞状细胞癌存在部分形态学相似性,但这一小队列的肿瘤表现出相对更优的预后,即便其有丝分裂计数和Ki-67指数显著升高。值得注意的是,长期随访的患者中仅 2 例因肿瘤死亡(分别在 4 年和 7 年后),这提示缺乏真正的神经内分泌表型可能为这些患者带来生存优势。由于部分研究表明,针对神经内分泌肿瘤的铂类联合依托泊苷化疗方案对LCNEC患者有益,因此需要更多大样本长期随访研究以进一步阐明这一观点。此外,采用更严格的LCNEC诊断标准,并认识到某些形态高度类似LCNEC的肿瘤可能完全缺乏神经内分泌标记物,对治疗方案的选择可能具有重要意义。
综上所述,研究人员提出了一种他们认为属于肺腺癌的不寻常变异型,其特征为大细胞形态伴显著的核周栅栏状排列,赋予其“基底样”外观。尽管该肿瘤在形态上与大细胞神经内分泌癌(LCNEC)高度相似,但其未显示任何免疫组化或超微结构层面的神经内分泌分化证据。识别此类肿瘤并对更多病例进行进一步临床病理研究,将有助于全面阐明其生物学行为。
我司实体瘤全外显子组基因检测、实体瘤1299基因检测、实体瘤272基因检测PLUS版均可覆盖了文中检出的KRAS 、TP53、KIT、FGFR1、GNAS基因,可同时进行RB1突变检测,辅助诊断、预后评估、靶向用药、免疫用药、化疗用药以及遗传风险评估,满足临床精准诊疗需求。
基因
参考文献:
Suster D, Mejbel HA, Mackinnon AC, Suster S. Large-cell Basaloid Adenocarcinoma of the Lung: A Clinicopathologic Study of 12 Cases of a Distinctive Form of Lung Cancer Often Mistaken for Large-cell Neuroendocrine Carcinoma. Am J Surg Pathol. 2025 Jan 1;49(1):83-93. doi: 10.1097/PAS.0000000000002318. Epub 2024 Oct 31. PMID: 39450943.